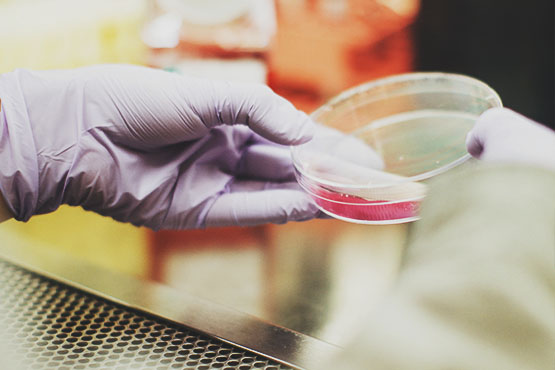
Convênio renovado garante exames de DNA gratuito por mais 6 meses em Santa Catarina

Geral
05/02/2019 13h45
Convênio renovado garante exames de DNA gratuito por mais 6 meses em Santa Catarina
Todas as comarcas do Estado estão cobertas pelo Programa para a coleta de material genético e para a realização dos exames.

O Tribunal de Justiça, Ministério Público, Universidade para o Desenvolvimento de Santa Catarina, Conselho de Secretarias Municipais de Saúde do Estado de Santa Catarina e o Instituto Paternidade Responsável renovaram neste início do ano, por mais seis meses, convênio que garante a realização dos exames de DNA para o reconhecimento de paternidade nos procedimentos administrativos e judiciais em que fique comprovada a hipossuficiência de recursos das partes.
Todas as comarcas do Estado estão cobertas pelo Programa para a coleta de material genético e para a realização dos exames, nos termos do procedimento instituído pela Resolução n. 03/2007- GP/CGJ.
A realização dos exames de DNA é feita pelo Laboratório de Análises Genéticas da Udesc em Lages. Após o fim do recesso e o retorno ao trabalho normal, os envelopes para análise começaram a chegar, oriundos de diversas comarcas do Estado.
Além do DNA gratuito, também podem ser realizados exames pagos, em escolha afeta as partes. O valor do exame varia entre R$ 400 e R$ 500, dependendo do laboratório. O laboratório do CAV, em Lages, é o único do estado que atende gratuitamente. A presidente do Instituto de Paternidade Responsável (IPR), Rosane Wiggers, comemorou a renovação do convênio, cuja validade se estende até 30 de julho deste ano.